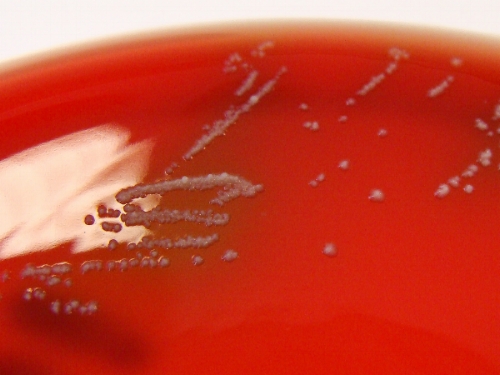
FIGURA 4. Colonias de Propionobacterium acnes, la bacteria responsable del acné.

Publicado en Revista Persea.
Léelo completo en su sitio: https://www.revistapersea.com/ciencias-de-la-vida/el-vino-es-mejor-en-compania
15/6/2017

Ilustración: Ada Peña
Después de una dura semana de trabajo me gusta disfrutar una copa de vino en compañía de mi pareja. El sabor y el aroma nos deleitan. Su efecto nos relaja, nos desinhibe, nos llena de gozo y suele estimular conversaciones exquisitas que muchas veces terminan ya saben cómo.
En una de esas conversaciones hablábamos de cuánta ciencia había en nuestras copas. De cuánta historia, cuánta humanidad, cuántas civilizaciones, culturas y pueblos que nos han precedido han disfrutado también de esa bebida. Imaginarse no sólo la procedencia directa del líquido en nuestra mano, sino ir aún más allá e imaginar las miles o millones de generaciones de agricultores, vides y microorganismos que han pasado hasta llegar al primer vino jamás creado, es un ejercicio que emociona y estimula nuestro intelecto. Preguntas complejas tipo ¿Cómo empezó todo? ¿Cómo fue la invención del vino? ¿Conocemos hoy absolutamente todo acerca de la producción de vino, sus fundamentos científicos? Son las que he intentado responder y cuyas respuestas, o al menos partes de ellas, compartiré con los lectores en el resto del texto.
El origen

FIGURA 1. Un joven griego sacando vino de un contenedor. Cerámica griega de los años 490 – 480 antes de Cristo.
Situémonos en el Neolítico. Es un día cualquiera hace más de 7000 años, plena Edad de Piedra, en los albores de la agricultura. Estamos en Asia central y una curiosa muchacha recolectora advierte que en el cuenco que usó para recolectar uvas silvestres días atrás, los restos de esas frutas nadan en un líquido extraño. Al beberlo, el sabor amargo probablemente se opacó con la sensación que tuvo después. Ha experimentado una ligera embriaguez que la cautivó a ella y luego a todo aquel que también lo probó. La suerte del vino estaba echada, su popularidad no haría sino expandirse.
Esta escena prehistórica tiene sus bases científicas. Han sido hallados restos de cuencos muy antiguos en excavaciones arqueológicas, cuyos análisis han sugerido que contuvieron vino. Se piensa que su descubrimiento fue por pura casualidad. Sin embargo, el momento y el sitio exacto de origen de la bebida permanecen difusos para la ciencia.
En el curso de la historia, y usando el sistema de prueba-error, diferentes culturas produjeron bebidas alcohólicas. Los pueblos de Asia, los griegos, celtas, vikingos, también los egipcios, babilonios y romanos producían vinos y cervezas a partir de uvas o cebada, respectivamente. Los pobladores americanos producían chicha a partir de frutas o maíz, y también el pulque de agave.
Durante la Edad Antigua, estos pueblos sabían que dejar frutas o granos en contenedores cubiertos durante días producirá vino o cerveza, pero sin saber el por qué. Durante el Imperio Romano ese proceso fue llamado fermentación, por la palabra latina fervere que significa «hervir». Ese nombre vino de la observación de que en las mezclas de uvas pisoteadas y cubiertas se producían burbujas, y pensaron que hervía.
Los productores de vino usualmente pisoteaban las uvas para ablandarlas y molerlas antes de dejarlas reposar en contenedores especiales. Sin saberlo, ellos transferían los microorganismos de sus pies a la mezcla. Tampoco sabían que la fermentación que venía después era causada por uno de esos microorganismos. Tomó cientos de años descubrir que unos microscópicos hongos unicelulares eran los responsables.
Levaduras
Fue en el siglo XVII cuando las levaduras fueron observadas por primera vez. Lo hizo Antoni van Leeuwenhoek, un comerciante holandés que perfeccionó los microscopios e inició una revolución científica con el descubrimiento de la vida microbiana y unicelular. Miró también por primera vez los espermatozoides, los glóbulos rojos, células vegetales y varios materiales inorgánicos. Por cierto, cuando vio las levaduras en la elaboración de cerveza y pan pensó que se trataba de unos diminutos granos inorgánicos, inertes, responsables de la fermentación de las bebidas y del levantamiento del pan. La palabra latina levare significa levantar, de ahí su nombre.
En el siglo siguiente, el XVIII, con los trabajos del químico francés Antoine Lavoisier y de su esposa Marie-Anne Pierrette, quedó más o menos claro que durante la fermentación los azúcares son convertidos en alcohol y dióxido de carbono (¿recuerdan lo de las burbujas?). Ellos sabían que las levaduras, esa extraña sustancia microscópica e «inerte», era necesaria para iniciar la fermentación, pero no supieron por qué. Luego vino otro químico francés, Joseph Gay-Lussac, y advirtió que el jugo de uvas no fermentan cuando se le lleva a ebullición, a menos que se introduzcan levaduras. La importancia de las levaduras estaba claro, pero ¿Cuál era su papel?
Ahora es 1835 y seguimos en Francia. El físico e ingeniero Charles Cagniard de la Tour observó que durante la fermentación las levaduras se multiplican por gemación. En la gemación, la levadura madre emite una protuberancia que se convertirá luego en otra levadura, es como si le brotaran los hijos (¿Recuerdan los Gremlins? Pues algo así). Este descubrimiento permitió reconocerlas como entidades vivas y allanó el camino para dilucidar finalmente el papel de las levaduras en la fermentación alcohólica.
Y vino el gran Louis Pasteur a mediados de 1800 y demostró experimentalmente, por primera vez, que las levaduras son las que transforman el jugo de uvas en vino, en ausencia de oxígeno (por eso los contenedores sellados), transformando los azúcares de las frutas en alcohol. Por otra parte, analizando barriles contaminados en una destilería francesa que en lugar de alcohol formaba una especie de leche agria, Luis Pasteur descubrió que existe otro tipo de fermentación, la fermentación láctica, la cual es llevada a cabo por bacterias. Esa fermentación es usada para la fabricación de quesos y yogures, pero eso es otra historia.
Ya iniciado el siglo XX, la fermentación pudo ser recreada in vitro usando el contenido celular de las levaduras. Eduard Buchner fue el químico alemán que secó, trituró y maceró levaduras para liberar su contenido; una especie de jugo de levaduras. A ese preparado añadió glucosa y observó que producía burbujas y alcohol. Postuló la existencia de una «zimasa», una sustancia en el interior de las levaduras responsable de llevar a cabo la transformación del azúcar. En 1907 recibió el premio Nobel de Química por su descubrimiento.

FIGURA 2. Personajes claves en la historia de la fermentación.
La naturaleza de la «zimasa» se dilucidó poco a poco hasta que, en 1940, el proceso bioquímico completo fue descrito. La zimasa era en realidad un grupo de varias enzimas distintas cuyas actividades proporcionan energía para la levadura en 10 reacciones químicas secuenciales: la glucólisis. Este proceso bioquímico es común en casi todos los seres vivos, solo que en nuestras células animales no finaliza con la liberación de alcohol (menos mal), sino de una molécula llamada piruvato.

FIGURA 3. Esquema simplificado del proceso de fermentación en levaduras. En la representación molecular, las esferas rojas son oxígeno, las blancas hidrógeno y las grises carbono.
Con el pasar del siglo XX y el inicio del XXI, el interés ha sido puesto en obtener mejores cepas de levaduras que aporten distinción a los vinos mediante fermentaciones controladas, pero también en el mejoramiento de las vides convencional mediante cruzamientos (el fitomejoramiento). Además, comprender mejor la histórica compañía entre uvas y levaduras ha sido clave para consolidar y mejorar la industria del vino. Y los descubrimientos no cesan.
Hablando de compañía…
En el año 2014 científicos italianos (Campisano et al.) publicaron un hallazgo sorprendente. Ellos estudiaban a las bacterias que viven en las vides, que en conjunto son llamadas microbioma vegetal. Un dato no cuadraba con la composición microbiana que esperaban: detectaban consistentemente el ADN de una bacteria que no debería estar ahí. Era como si al analizar fotos tomadas en un bosque tropical, se advirtiera la presencia de osos polares. La bacteria «intrusa» era Propionobacterium acnes, la bacteria responsable del acné. Lo más lógico fue pensar que se trataba de una contaminación al manipular las muestras; por ejemplo, el técnico pudo haber pasado las bacterias desde sus manos hacia las muestras. Sin embargo, luego de muchos análisis descartaron esa posibilidad.
Descubrieron también que justo esa Propionobacterium acnes es incapaz de reproducirse o de vivir sin la planta: es una bacteria endófita obligada, vive exclusivamente en los tejidos internos de la vid. Ella acumula una cantidad de mutaciones que entorpecen su capacidad de sobrevivir como un microorganismo autónomo y vive exclusivamente en los tejidos internos de las vides. Siguiendo las trazas de esas mutaciones y considerando la velocidad de los cambios evolutivos y los tiempos generacionales de las vides y de bacterias similares, llegaron a la conclusión de que esa bacteria fue adquirida por la planta entre 6300 y 7500 años atrás, en el Neolítico. Posteriormente, los procesos de domesticación y fitomejoramiento han seleccionado a las plantas que portaban a esta bacteria. (Los autores del trabajo la han llamado Propionobacterium acnes Zappae, como tributo al excéntrico compositor Frank Zappa, para resaltar el hábitat inesperado y nada convencional de esta bacteria).
FIGURA 4. Colonias de Propionobacterium acnes, la bacteria responsable del acné.
¿Se acuerdan de la muchacha recolectora que descubrió el vino por casualidad? Pues ella bien pudo haber sufrido de acné y haber transferido sus bacterias a las plantas que manipulaba. Luego, sin conocer aún por qué, aquellos pobladores seleccionaron las plantas que portaban a Propionobacterium consigo. Probablemente la bacteria hacía que algún rasgo deseado de la planta mejorase (¿Robustez? ¿Frutos más grandes? ¿Resistencia a enfermedades?…) y fue fijada en el largo proceso de domesticación de la planta; por eso probablemente todas las vides modernas cargan consigo esa perenne compañía.
La observación y la experimentación han sumado piezas para la reconstrucción de la historia, composicion y fabricacion del vino. Hoy en día, las modernas técnicas de análisis, ingeniería genética y de fitomejoramiento expanden el repertorio de variedades de vides y levaduras, que amplifican la oferta y variedades de vino. Más allá del valor histórico y científico de esta bebida, su importancia socioeconómica es innegable. Países de nuestra región como Chile y Argentina están entre los mayores productores de vino del mundo. Sus industrias viníferas proporcionan considerables aportes a sus producto interno bruto y emplean a millares de personas. Y lejos de haberse detenido, los descubrimientos que rodean al vino nos seguirán sorprendiendo.
Brindemos (con moderación) por el vino, por la ciencia y por las buenas compañías. ¡Salud!
Para saber más:
- Alba-Lois y Segal-Kischinevzky. (2010). Yeast fermentation and the making of beer and wine. Nature Education, 3(9), p. 17.
- Chambers y Pretorius. (2010). Fermenting knowledge: the history of winemaking, science and yeast research. EMBO reports, 11(12), pp. 914.
- Campisano et al. (2014). Interkingdom transfer of the acne causing agent, Propionibacterium acnes, from human to grapevine. Molecular Biology and Evolution, 31(5), pp. 1059-1065.
